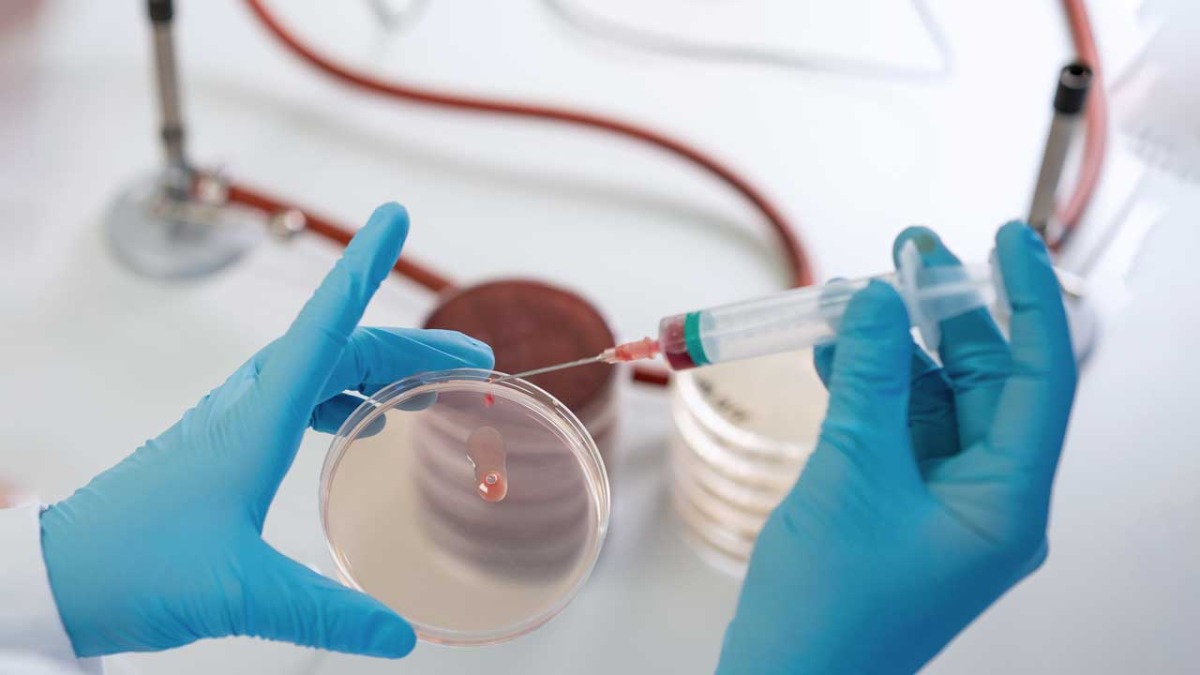
Laboratory

Cancer patients are living longer than ever, but what are the costs of treatment side effects on quality of life? Hannah Wardill at the University of Adelaide, Australia, is delving into the gut microbiome to see if it can predict these side effects, while also investigating microbial treatments that might alleviate them.
One of the big challenges in cancer treatment is that the side effects are really unpredictable, which makes it difficult to prepare patients for what’s going to come next.
Hannah Wardill PhD, Supportive Oncology Research Group,
University of Adelaide
Many patients are hesitant to even discuss them [treatment side-effects], either because it concerns bowel habits or because they feel ungrateful.
Hannah Wardill PhD, Supportive Oncology Research Group,
University of Adelaide
University of Adelaide
We have been looking at how a person’s unique microbiome impacts their response to chemotherapy and whether it can predict which side effects they will develop.
Hannah Wardill PhD, Supportive Oncology Research Group,
University of Adelaide
University of Adelaide
We hope that by matching both immune cells and microbes, we might have a more tolerant immune system and fewer side effects that occur when the donated stem cells behave aggressively.
Hannah Wardill PhD, Supportive Oncology Research Group,
University of Adelaide
University of Adelaide
March 2024
Related content
References:
1. Geller LT, et.al. Intratumoral bacteria may elicit chemoresistance by metabolizing anticancer agents. Mol Cell Oncol. 2017;5(1): e1405139.2. Najmi M, et. al. Modulation of the Gut Microbiome to Enhance Immunotherapy Response in Metastatic Melanoma Patients: A Clinical Review. Dermatol Ther. (Heidelb). 2022;12(11):2489-2497.